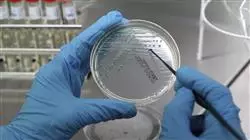
##IMAGE##

Qualificação universitária
A maior faculdade de Medicina do mundo”
Apresentação
Esta capacitação irá criar uma sensação de segurança no desempenho da prática médica, que o ajudará a crescer a nível pessoal e profissional”

A escala e a complexidade dos dados genómicos diminuem as medidas tradicionalmente usadas em testes de laboratório. Nos últimos anos, registou-se um enorme desenvolvimento da tecnologia informática para analisar e interpretar a sequenciação de ADN, o que criou um desfasamento entre o conhecimento biológico e a sua aplicação na prática clínica. É, portanto, necessário educar, divulgar e também incorporar estas técnicas informáticas entre a comunidade médica para poder interpretar a análise massiva de dados provenientes de publicações, bases de dados biológicos ou médicos e historiais clínicos, entre outros, e assim poder enriquecer a informação biológica disponível a nível clínico.
Esta aprendizagem automática permitirá o desenvolvimento da Oncologia de Precisão, com o objetivo de interpretar as caraterísticas genómicas e encontrar terapias específicas, ou identificar os riscos de certas doenças e estabelecer medidas preventivas mais individualizadas. Um objetivo fundamental da capacitação é aproximar e divulgar conhecimentos informáticos, já aplicados noutras áreas do conhecimento, mas que têm uma implementação mínima no mundo da medicina, apesar de, para que a Medicina Genómica se torne uma realidade, ser necessário interpretar com precisão o enorme volume de informação clínica atualmente disponível e associá-lo aos dados biológicos gerados após uma análise bioinformática. Embora este seja um desafio difícil, isto permitirá que os efeitos da variação genética e potenciais terapias sejam explorados rapidamente, de forma económica e com maior precisão do que é possível atualmente.
Os humanos não estão naturalmente equipados para perceber e interpretar sequências genómicas, nem para compreender todos os mecanismos, vias e interações que ocorrem no interior de uma célula viva, nem para tomar decisões médicas com dezenas ou centenas de variáveis. Para avançar, é necessário um sistema com capacidade analítica sobre-humana que simplifique o ambiente de trabalho e que mostre as relações e proximidades entre as variáveis. Em Genómica e Biologia, sabe-se que é melhor gastar os recursos em novas técnicas computacionais do que na mera recolha de dados, algo que possivelmente também se aplica à Medicina e, claro, à Oncologia.
Atualize os seus conhecimentos com o Curso de Especialização em Oncologia Genómica e de Precisão”
O Curso de Especialização em Oncologia Genómica e de Precisão conta com o conteúdo científico mais completo e atualizado do mercado. As suas principais características são:
- O desenvolvimento de casos práticos apresentados por especialistas em Oncologia Genómica e de Precisão Os seus conteúdos gráficos, esquemáticos e predominantemente práticos fornecem informações científicas e práticas sobre aquelas disciplinas indispensáveis para a atividade profissional
- Últimos desenvolvimentos em Oncologia Genómica e de Precisão
- Conta com exercícios práticos onde o processo de autoavaliação pode ser levado a cabo a fim de melhorar a aprendizagem
- Com foco especial nas metodologias inovadoras em Oncologia Genómica e de Precisão
- Tal será complementado por aulas teóricas, perguntas ao especialista, fóruns de discussão sobre temas controversos e atividades de reflexão individual
- Disponibilidade de acesso aos conteúdos a partir de qualquer dispositivo fixo ou portátil com ligação à Interne
Este Curso de Especialização pode ser o melhor investimento que fará ao selecionar um curso de atualização por duas razões: além de atualizar os seus conhecimentos sobre Oncologia Genómica e de Precisão, também obterá um certificado da TECH Universidade Tecnológica”
O seu corpo docente inclui profissionais do setor da Oncologia Genómica e de Precisão, que trazem a sua experiência profissional para esta capacitação, bem como especialistas reconhecidos de empresas líderes e universidades de prestígio.
Graças ao seu conteúdo multimédia desenvolvido com a mais recente tecnologia educacional, o Curso de Especialização permitirá ao profissional ter acesso a uma aprendizagem situada e contextual, ou seja, um ambiente de simulação que proporcionará uma aprendizagem imersiva programada para praticar em situações reais.
A conceção desta capacitação baseia-se na Aprendizagem Baseada nos Problemas, através da qual o estudante deverá tentar resolver as diferentes situações da atividade profissional que surgem ao longo do Curso de Especialização. Para isso, o estudante contará com a ajuda de um inovador sistema de vídeo interativo, realizado por especialistas reconhecidos na área da Oncologia Genómica e de Precisão e com ampla experiência de ensino.
Aumente a sua confiança na tomada de decisões, atualizando os seus conhecimentos através deste Curso de Especialização"

Aproveite a oportunidade para conhecer os últimos avanços em Oncologia Genómica e de Precisão e melhorar o atendimento aos seus pacientes"
Objectivos
O Curso de Especialização em Oncologia Genómica e de Precisão visa auxiliar o desempenho do médico que se dedica ao tratamento da patologia oncológica, na qual é necessário interpretar com precisão um grande volume de informações clínicas atualmente disponíveis e associá-lo com os dados biológicos gerados após uma análise bioinformática.
Este Curso de Especialização foi desenvolvido para o ajudar a atualizar os seus conhecimentos em Oncologia Genómica e de Precisão, com o uso da mais recente tecnologia educacional, para contribuir com qualidade e segurança para a tomada de decisões”
Objetivo geral
-
Ser capaz de interpretar com precisão o volume de informações clínicas atualmente disponíveis e associadas aos dados biológicos gerados após a análise bioinformática
Objetivos específicos
Módulo 1. Biologia Molecular
- Atualizar os conhecimentos sobre a Biologia Molecular do Cancro, em relação a diferentes conceitos como a heterogeneidade genética ou a reprogramação do microambiente
- Fornecer e expandir conhecimentos sobre imunoterapia como um exemplo de um claro avanço científico na investigação translacional
- Conhecer uma nova abordagem para classificar os tumores mais comuns com base em dados genómicos disponíveis em The Cancer Genome Atlas (TCGA) Research Network
Módulo 2. Oncologia Genómica ou de Precisão
- Discutir a evolução do panorama com a introdução de dados genómicos na compreensão biológica dos tumores
- Explicar como a classificação genómica fornece informações independentes para prever resultados clínicos e constituirá a base biológica para uma era de tratamentos personalizados do cancro
- Conhecer as novas tecnologias genómicas atualmente utilizadas na sequenciação do ADN e do ARN, baseadas na sequência do genoma humano e tornadas possíveis desde a conclusão do
- Projeto Genoma Humano, o que significou uma expansão sem precedentes das capacidades da genética
- molecular na investigação genética e de diagnóstico clínico
- Discutir o processo bioinformático utilizado para a interpretação e aplicação de dados biológicos
- Analisar e interpretar informações biológicas a nível molecular, celular e genómico
Módulo 3 Mudanças na prática clínica atual e novas aplicações com a Oncologia Genómica
- Discutir e interpretar a carga mutacional tumoral (TMB) como um biomarcador genómico que tem um impacto significativo no panorama da imunoterapia do cancro
- Aprender como a biopsia líquida do ADN circulante nos permite compreender especificamente que tipo de alterações moleculares estão a ocorrer no tumor em tempo real
- Descrever o paradigma atual de incorporação de dados genómicos na prática clínica corrente
Módulo 4 Novas técnicas na era genómica
- Colocar em prática os conhecimentos adquiridos na interpretação de um estudo genómico em vários casos de cancro, extraindo informações úteis para ajudar na tomada de decisões
- Utilizar vários algoritmos realizados com a linguagem R para a extração de conhecimento das bases de dados Pubmed, DGIdb e Clinical Trials a partir da pesquisa de informação genética em determinados tumores

Aproveite a oportunidade e tome a iniciativa de se atualizar quanto aos últimos desenvolvimentos em Oncologia Genómica e de Precisão"
Curso de Especialização em Oncologia Genómica e de Precisão
A Oncologia tem sido alimentada por diferentes áreas do conhecimento ao longo do tempo, atualmente, a medicina genómica apresenta-se como uma excelente oportunidade de progresso profissional, uma vez que proporciona novas alternativas de desenvolvimento neste exigente ramo do conhecimento. Na TECH Universidade Tecnológica procuramos oferecer uma excelente oportunidade de formação académica, razão pela qual concebemos o mais completo e atualizado Especialista Universitário em Oncologia Genómica e de Precisão no campo da educação. O nosso programa conta com um plano de estudos inovador que proporcionará aos alunos conhecimentos suficientes para que possam interpretar com exatidão o volume de informação fornecida nos diferentes estudos realizados. Além disso, ao longo do curso, irá adquirir uma compreensão do papel da resposta imune no controlo do cancro e dos mecanismos moleculares envolvidos no processo de invasão e metástase.
Estude uma pós-graduação em oncologia genómica virtualmente
Na TECH compreendemos perfeitamente como é exigente estar na vanguarda dos constantes avanços no campo da oncologia, pelo que no nosso curso de pós-graduação incorporamos novos eixos temáticos que permitem aos alunos interiorizar os seguintes tópicos: biologia molecular, novas técnicas na era genómica, mudanças na prática clínica atual, abordagens de imunoterapia, bem como outras abordagens teóricas de extrema importância para se qualificarem como um indivíduo com as melhores competências técnicas e conceptuais. Conhecerão também as novas tecnologias utilizadas na sequenciação de DNA e RNA, com base na sequência do genoma humano.







